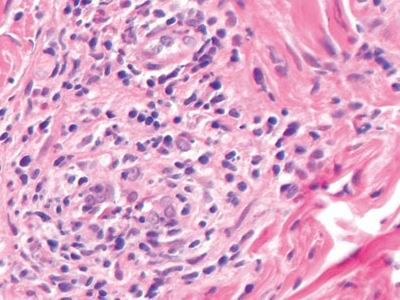

北京京城皮肤医院提供网络预约挂号服务
预约挂号热线:010-64888999
 三级专科
三级专科
 医保定点
医保定点
 舒适环境
舒适环境
 无假日
无假日
生殖器疱疹危害有什么?生殖器疱疹是性病当中发病率较高的。许多患者如果患上此病就感觉是一件很不光彩的事情,常常要面子,怕被别人知道,从而拒绝接受治疗,就会造成病情越来越重。其危害很大,发现疾病要及时治疗,那么生殖器疱疹危害有什么?下面我们听听北京京城皮肤医院的介绍。
危害一:如果患病初期,不及时的去医院接受检查治疗,而轻视病情这样会导致多种并发症的出现这也是生殖器疱疹较严重的危害表现。如果耽误了生殖器疱疹的较佳治疗不但会导致病情的加重还会引发很多种疾病。虽然生殖器疱疹的危害很大,但患者只要选择正规的医院和积的配合进行治疗,就会很的避免疱疹带给我们的巨大危害。
危害二:随着生殖器疱疹病情的复发与加重,生殖器疱疹的患者思想压力较大,患者的心情就会受到影响而出现心理障碍,发生抑郁症,还会导致患者容易患有其他泌尿系统疾病。患者怕传染给性伴侣不愿与异性交往而造成性功能障碍下降,甚至会造成有的男性患者又患上不孕症,影响到男性患者的正常生育功能。如果不及时治疗还会造成交叉感染。
危害三:生殖器疱疹的病发经常会使患者的心理负担加重,如果女性生殖器疱疹患者怀孕时患上生殖器疱疹,那么将会传染给宝宝,导致宝宝先天畸形或者智力受到很大影响。婴儿生下后*会很差抵抗力也特别弱,也有些孕妇感染后会导致流产特别严重者会使孕妇和新生婴儿都死亡。生殖器疱疹是传染性强的疾病,所以为了自己和家人的健康,一定的早预防、早治疗。
温馨提示:目前生殖器疱疹的治疗方法有很多,也有好多不正规的小医院为了谋取利益采用不良手段来欺骗患者,让许多患者的病情不见好转还导致更加严重。因此,患者在选择医院的时候一定要谨慎。切记不可乱投医,这样对患者的病情是非常不利的,所以一定得去正规医院接受治疗。